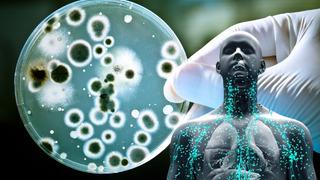
Aman dikkat: Ölümcül bakteri uyarısı! Vampir gibi insan kanından besleniyor

Bakteri Haberleri Ve Son Dakika Bakteri Haberleri
Bakteri haberleri sayfasında, bakterilerle ilgili en son gelişmeleri, güncel haberleri ve bilimsel araştırmaları bulabilirsiniz. Bakteri dünyası, sağlık, çevre ve biyoteknoloji alanında önemli bir rol oynamaktadır. Son zamanlarda yapılan araştırmalar, bakterilerin insan sağlığı üzerindeki etkilerini ve mikropların çeşitli hastalıklarla ilişkisini daha iyi anlamamıza yardımcı olmaktadır.
Bu sayfada yer alan bakteri gelişmeleri, okuyuculara bakterilerin doğası, çeşitliliği ve bilimsel önemine dair bilgi verecektir. Ayrıca, son dakika bakteri haberleri ile bu alandaki öncü çalışmalar ve keşiflerle ilgili güncel içeriklere de ulaşma fırsatı bulacaksınız. Bakteri ile ilgili her türlü bilgiye ulaşabileceğiniz bu sayfa, merak edenler için zengin bir kaynak sunmaktadır.

Haber Gönder
Haber Gönder